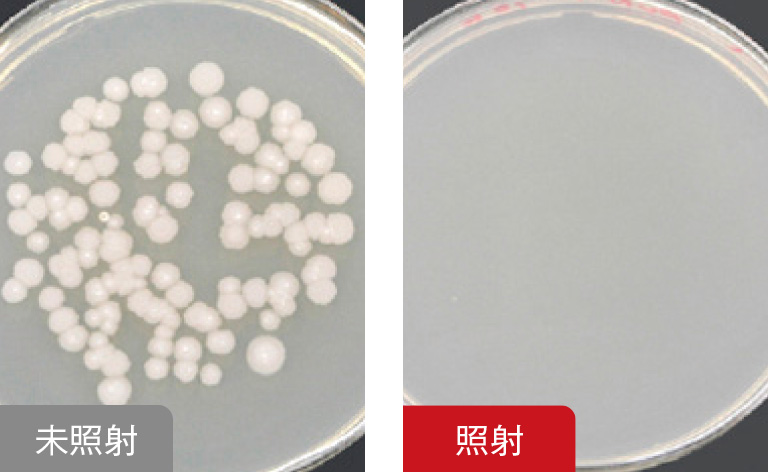

Japan (JA)
国・地域を選択してください。


応用分野と事例 | 低エネルギー電子線照射源
電子線による化学反応
電子線照射は、材料にエネルギーを与えて分子レベルで構造を変化させる技術です。照射によりラジカルが生成され、これを起点に「架橋」「分解」「グラフト重合」という3つの主要反応が進行します。これらの反応を組み合わせることで、材料に多様な機能を付与できます。
架橋

分子鎖同士が結合し、三次元ネットワーク構造を形成します。耐熱性・耐薬品性・機械的強度の向上が期待できます。
分解

高分子鎖が切断され、低分子化します。
滅菌やポリマーの低分子化、表面改質などの効果が期待できます。
グラフト重合

基材表面に新しいモノマーを結合させ、機能性を付与します。親水性膜の生成や耐薬品性の向上が期待できます。
化学反応の事例:グラフト重合
電子線を照射していない樹脂は見た目に変化がありませんが、照射した樹脂では光沢が見られ、グラフト重合が進んだことがわかります。

提供:大阪大学 産業科学研究所 大島明博様
具体的な応用事例と電子線効果
印刷

電子線照射は、塗料や接着剤、インキなどの液状樹脂を短時間で硬化させる「キュアリング」に利用されます。この方法は有機溶剤、反応開始剤(光開始剤など)を不要とし、環境負荷を低減できるほか、熱や臭気の発生を抑え、作業環境改善にも貢献します。
印刷の実例:EBインキの乾燥
電子線の照射前はテープにインキが付着していますが、照射後はインキが硬化し基材に密着したことで、テープに付着しません。

印刷機・印刷装置への搭載イメージ動画
産業部品加工

電子線照射により、材料の耐熱性・耐薬品性・機械的強度を大幅に向上させます。添加剤やコーティング剤を使用せずに改質できる点が特徴的で、電線被覆、タイヤ、フィルムなどの高機能化に広く利用されています。
産業部品加工の実例:耐摩耗性の向上
電子線を照射していない樹脂には研磨による摩耗の後がついていますが、照射した樹脂にはほとんど痕がついていません。

業界応用例:自動車部品の高機能化
架橋:ベアリングの耐久性向上

ベアリング等の摺動製部品に用いられる樹脂を架橋させることで耐久性を向上させることで、部品寿命の延長によるメンテナンス性の改善が期待できます。
架橋:タイヤの製造工程に利用し材料削減

タイヤの製造工程で電子線を活用し、予備架橋することで品質向上、材料削減に貢献できます。
キュアリング:塗料の硬化で環境対応

自動車のボディをはじめとする塗装が必要な部材にEB硬化型の塗料を用いることで品質向上、省エネが期待できます。
医療用器具の滅菌

電子線は、微生物のDNAや細胞膜を損傷させることで滅菌効果を発揮します。作用には2種類あり、電子線がDNAを直接切断する「直接作用」と、水分子との反応で生成したラジカルがDNAを攻撃する「間接作用」です。この方法は化学薬品を使用せず、高い滅菌効果を短時間で得られるため、医療機器や食品包装など幅広い分野で利用されています。
滅菌応用の実例:枯草菌の滅菌
電子線を照射していないシャーレの枯草菌は増殖していますが、照射したシャーレの枯草菌は増殖していません。
提供:一般社団法人 浜松市薬剤師会 浜松環境衛生研究所
業界応用例:医療業界におけるドライプロセスでの表面処理
滅菌:シャーレの外装滅菌

シャーレなどをはじめとする医療用器具の滅菌が可能です。バイアル瓶やシリンジ、錠剤包装材など、さまざまな器具・製品の滅菌に応用できます。
架橋:手術室用品の強度や耐熱性の向上

ボルトや細胞シート、縫合糸など、手術室で用いる器具の表面機能性をドライプロセスで向上できます。
キュアリング:錠剤パッケージの印刷

電子線を用いてインキ乾燥を行うことで、マイグレーションを抑えた印刷が可能です。錠剤パッケージ以外にも輸液パックなどの医療用製品の印刷にも応用できます。
- Confirmation
-
It looks like you're in the . If this is not your location, please select the correct region or country below.
You're headed to Hamamatsu Photonics website for JP (Japanese). If you want to view an other country's site, the optimized information will be provided by selecting options below.
In order to use this website comfortably, we use cookies. For cookie details please see our cookie policy.
- Cookie Policy
-
This website or its third-party tools use cookies, which are necessary to its functioning and required to achieve the purposes illustrated in this cookie policy. By closing the cookie warning banner, scrolling the page, clicking a link or continuing to browse otherwise, you agree to the use of cookies.
Hamamatsu uses cookies in order to enhance your experience on our website and ensure that our website functions.
You can visit this page at any time to learn more about cookies, get the most up to date information on how we use cookies and manage your cookie settings. We will not use cookies for any purpose other than the ones stated, but please note that we reserve the right to update our cookies.
1. What are cookies?
For modern websites to work according to visitor’s expectations, they need to collect certain basic information about visitors. To do this, a site will create small text files which are placed on visitor’s devices (computer or mobile) - these files are known as cookies when you access a website. Cookies are used in order to make websites function and work efficiently. Cookies are uniquely assigned to each visitor and can only be read by a web server in the domain that issued the cookie to the visitor. Cookies cannot be used to run programs or deliver viruses to a visitor’s device.
Cookies do various jobs which make the visitor’s experience of the internet much smoother and more interactive. For instance, cookies are used to remember the visitor’s preferences on sites they visit often, to remember language preference and to help navigate between pages more efficiently. Much, though not all, of the data collected is anonymous, though some of it is designed to detect browsing patterns and approximate geographical location to improve the visitor experience.
Certain type of cookies may require the data subject’s consent before storing them on the computer.
2. What are the different types of cookies?
This website uses two types of cookies:
- First party cookies. For our website, the first party cookies are controlled and maintained by Hamamatsu. No other parties have access to these cookies.
- Third party cookies. These cookies are implemented by organizations outside Hamamatsu. We do not have access to the data in these cookies, but we use these cookies to improve the overall website experience.
3. How do we use cookies?
This website uses cookies for following purposes:
- Certain cookies are necessary for our website to function. These are strictly necessary cookies and are required to enable website access, support navigation or provide relevant content. These cookies direct you to the correct region or country, and support security and ecommerce. Strictly necessary cookies also enforce your privacy preferences. Without these strictly necessary cookies, much of our website will not function.
- Analytics cookies are used to track website usage. This data enables us to improve our website usability, performance and website administration. In our analytics cookies, we do not store any personal identifying information.
- Functionality cookies. These are used to recognize you when you return to our website. This enables us to personalize our content for you, greet you by name and remember your preferences (for example, your choice of language or region).
- These cookies record your visit to our website, the pages you have visited and the links you have followed. We will use this information to make our website and the advertising displayed on it more relevant to your interests. We may also share this information with third parties for this purpose.
Cookies help us help you. Through the use of cookies, we learn what is important to our visitors and we develop and enhance website content and functionality to support your experience. Much of our website can be accessed if cookies are disabled, however certain website functions may not work. And, we believe your current and future visits will be enhanced if cookies are enabled.
4. Which cookies do we use?
There are two ways to manage cookie preferences.
- You can set your cookie preferences on your device or in your browser.
- You can set your cookie preferences at the website level.
If you don’t want to receive cookies, you can modify your browser so that it notifies you when cookies are sent to it or you can refuse cookies altogether. You can also delete cookies that have already been set.
If you wish to restrict or block web browser cookies which are set on your device then you can do this through your browser settings; the Help function within your browser should tell you how. Alternatively, you may wish to visit www.aboutcookies.org, which contains comprehensive information on how to do this on a wide variety of desktop browsers.
5. What are Internet tags and how do we use them with cookies?
Occasionally, we may use internet tags (also known as action tags, single-pixel GIFs, clear GIFs, invisible GIFs and 1-by-1 GIFs) at this site and may deploy these tags/cookies through a third-party advertising partner or a web analytical service partner which may be located and store the respective information (including your IP-address) in a foreign country. These tags/cookies are placed on both online advertisements that bring users to this site and on different pages of this site. We use this technology to measure the visitors' responses to our sites and the effectiveness of our advertising campaigns (including how many times a page is opened and which information is consulted) as well as to evaluate your use of this website. The third-party partner or the web analytical service partner may be able to collect data about visitors to our and other sites because of these internet tags/cookies, may compose reports regarding the website’s activity for us and may provide further services which are related to the use of the website and the internet. They may provide such information to other parties if there is a legal requirement that they do so, or if they hire the other parties to process information on their behalf.
If you would like more information about web tags and cookies associated with on-line advertising or to opt-out of third-party collection of this information, please visit the Network Advertising Initiative website http://www.networkadvertising.org.
6. Analytics and Advertisement Cookies
We use third-party cookies (such as Google Analytics) to track visitors on our website, to get reports about how visitors use the website and to inform, optimize and serve ads based on someone's past visits to our website.
You may opt-out of Google Analytics cookies by the websites provided by Google:
https://tools.google.com/dlpage/gaoptout?hl=en
As provided in this Privacy Policy (Article 5), you can learn more about opt-out cookies by the website provided by Network Advertising Initiative:
http://www.networkadvertising.org
We inform you that in such case you will not be able to wholly use all functions of our website.
Close














































































































